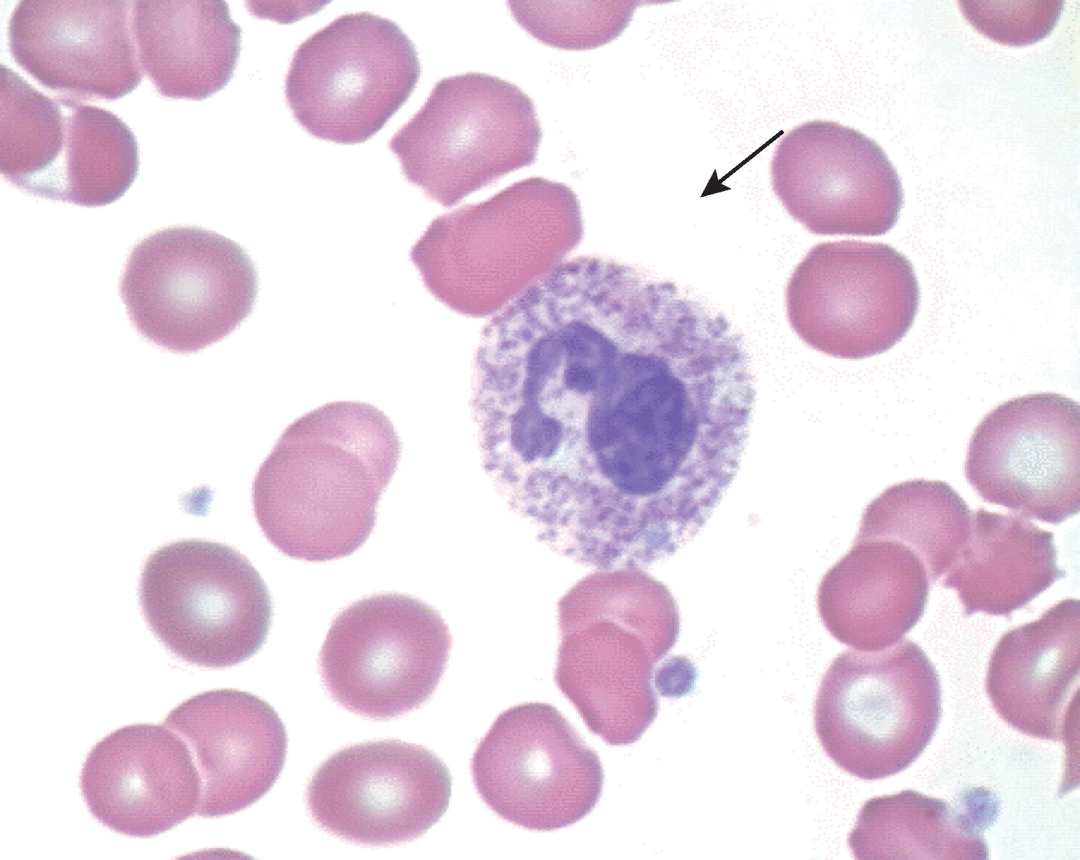
如何识别白细胞病理形态异常_中性_血细胞_颗粒

白细胞形态

教材疑点通你不知道的白细胞
图片尺寸1080x1022
都知道,上面三张照片所选的观察部位并不适合进行白细胞形态学的观察
图片尺寸800x612
白细胞
图片尺寸2000x1500
白细胞
图片尺寸1200x900
临床基础检验技术 #白细胞形态鉴别 #显微镜下的世界
图片尺寸1080x1081
白细胞
图片尺寸1200x900
免疫白细胞图片
图片尺寸300x300
查看 扎手指,白细胞18,血小板四百多.
图片尺寸1280x960
白细胞
图片尺寸1200x900
白细胞,显微镜,水平画幅,无人,白血病
图片尺寸1200x900
白细胞,显微镜,水平画幅,无人,白血病
图片尺寸1200x900
400倍显微镜下尿液标本的白细胞.
图片尺寸1100x1131
白细胞
图片尺寸1160x1100
白细胞 红细胞 人的血细胞彩图 血小板
图片尺寸1080x810
如何识别白细胞病理形态异常_中性_血细胞_颗粒
图片尺寸1080x860
白细胞3d模型
图片尺寸2560x1384
外周血白细胞知多少
图片尺寸640x480
为什么有些疾病引起白细胞增多?
图片尺寸1200x900![该图为血涂片,瑞氏染色,图中箭头所示的白细胞是? [图].](https://i.ecywang.com/upload/1/img2.baidu.com/it/u=1612709969,2051806636&fm=253&fmt=auto&app=138&f=JPEG?w=729&h=479)
该图为血涂片,瑞氏染色,图中箭头所示的白细胞是? [图].
图片尺寸729x479
白细胞.
图片尺寸1200x779










![该图为血涂片,瑞氏染色,图中箭头所示的白细胞是? [图].](https://i.ecywang.com/upload/1/img2.baidu.com/it/u=1612709969,2051806636&fm=253&fmt=auto&app=138&f=JPEG?w=729&h=479)

![该图为血涂片,瑞氏染色,图中箭头所示的白细胞是? [图].](https://static.jiandati.com/70fde5a-chaoxing2016-383013.jpeg)